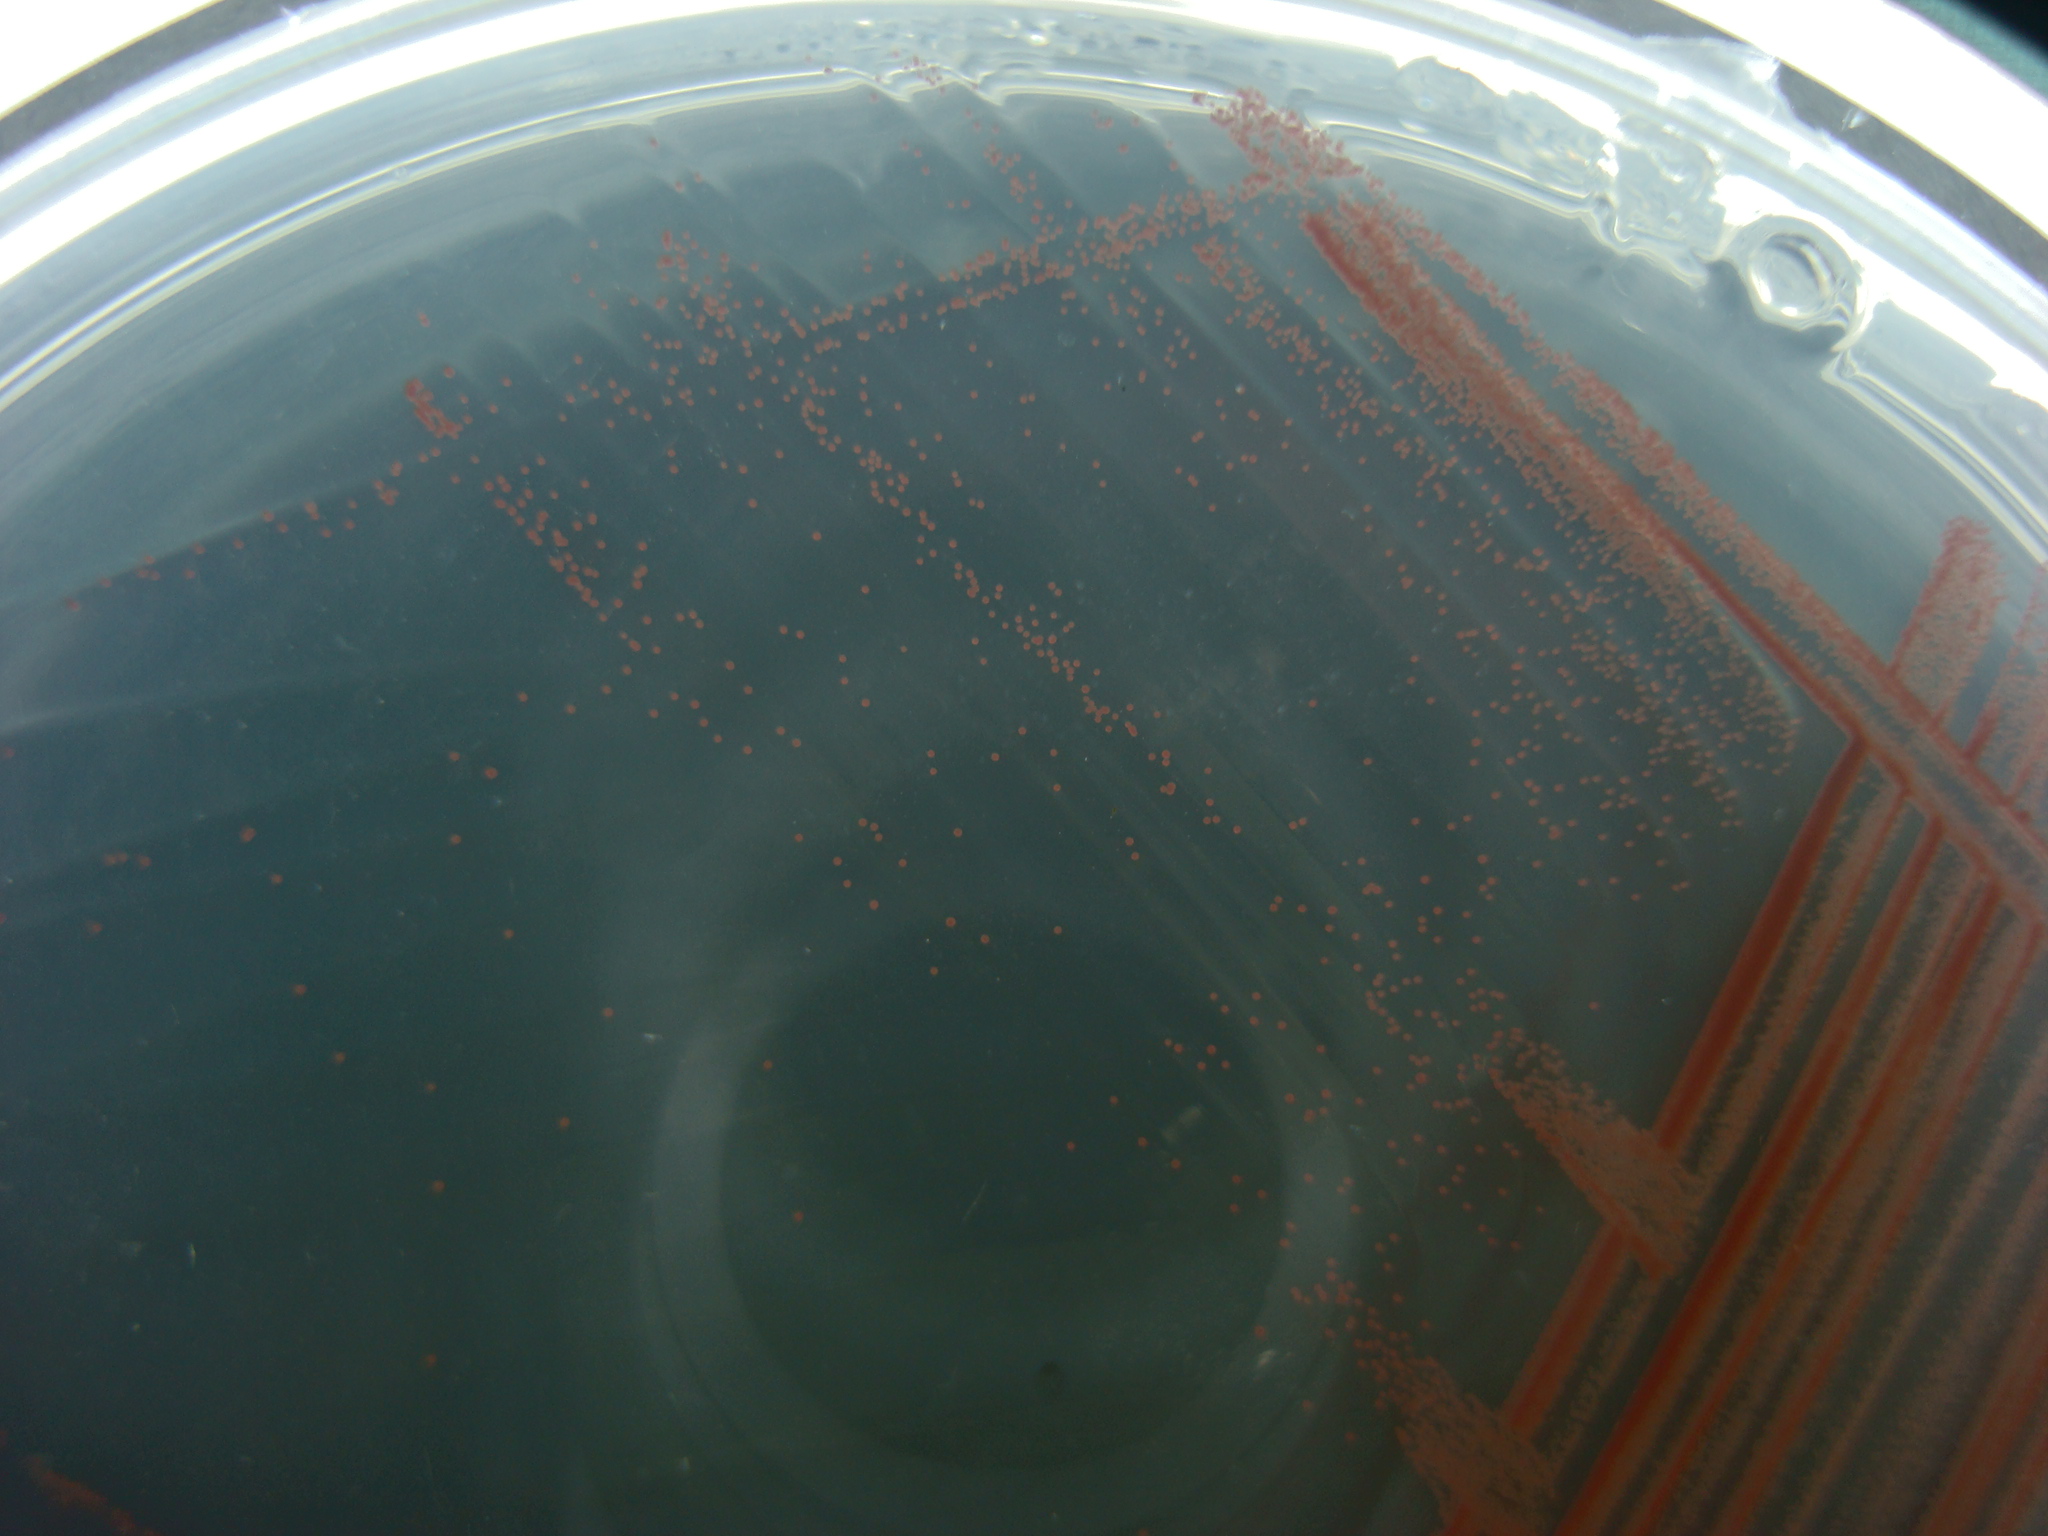

厭氧脫氮珠使用方法及預期效果
您是否對魚缸中硝酸鹽累積爆紅感到困擾,甚至硝化菌也無法抑制,除了換水、加吸附劑之外,難道只能裝設昂貴的化除器或增加有硫化氫風險的厭氧層嗎?有沒有更天然有效的處理方法?
光合細菌 (photosynthetic bacteria),是一群具有原始光合成系統的格蘭式陰性菌,光合細菌可在有光、無光、好氧、厭氧環境下,進行不同的異營及自營性功能(固氮、脫氮、固碳、氧化硫化物等),與自然界中的元素循環有著緊密的關係,對於自然環境的自淨作用,擔任舉足輕重的角色 (Hunter et al., 2009; Pfennig, 1967)。

另外,由於光合菌的細胞內含豐富之蛋白質(粗蛋白含量57.95%)、粗脂肪為7.9%,可溶性糖類為20.8%,並含有16種必需胺基酸、類胡蘿蔔素、生物輔因子等營養物質(Kobayashi and Tchan, 1973; Kobayashi, 1977; Mitsui, 1979),也相當適合作為飼料添加劑或直接餵食,尤其是原本就會食用細菌群落的小型觀賞蝦,更能達到提高育成率及增豔增體之效果,加上本身具有淨化水質功能,不論作為微生物活餌大量持續提供,或作為假期飼料皆合宜。
使用說明
作為濾材使用
每100公升水量使用10ml刻度之固形物(淡海水皆可),可依需求增減,因為保存液是含硫的培養基,有點味道是正常的,開封後需冷藏,若液面發霉不影響效果,去除黴菌(非水黴也不會影響魚蝦)即可使用。
建議使其維持在滾動照光的情況下(與K1濾材類似),效果較佳,可將保特瓶上下方打洞接打氣管自製,或用現成的透明流化床過濾器(注意孔徑大小不要讓珠子跑出即可)。
也可直接灑佈在缸底或置於濾材層中,有照光效果會較好。

或是用網袋包起來置於水流處,使用方式相當方面有彈性


(圖片由魚友提供)
剛使用第一周效果最佳(滾動照光)。
根據實測,使用頭一周即可降低硝酸鹽濃度約10~30%,與未使用相比(皆有添加硝化菌),硝酸鹽累積幅度大幅縮小近6成。
此外,由於晶球會逐漸被分解變小(溫度越高速度越快),脫氮效果亦隨時間遞減,約1~2周需補充一次(舊有晶球無需移除,會縮小至消失)。
建議搭配水色職人溫和硝化菌使用,降硝酸效果更明顯。
作為飼料使用
由於原料跟果凍相同,是全可食用性的,魚蝦皆可安心食用,且由於活菌被包覆在果凍結構中,故不會造成水霧及不汙染水質(反而有淨化水質功能),使用方式同一般沉底飼料,吃不完也無需撈除,光合菌具有相當高的營養成分,也是蝦類的天然食物,其蛋白質含量高達57.9%、脂肪7.9%、碳水化合物20.8%,並含有16種必需胺基酸等養分,適合作為觀賞蝦蝦苗飼料或成蝦餌料、假期飼料、開口餌料等使用。